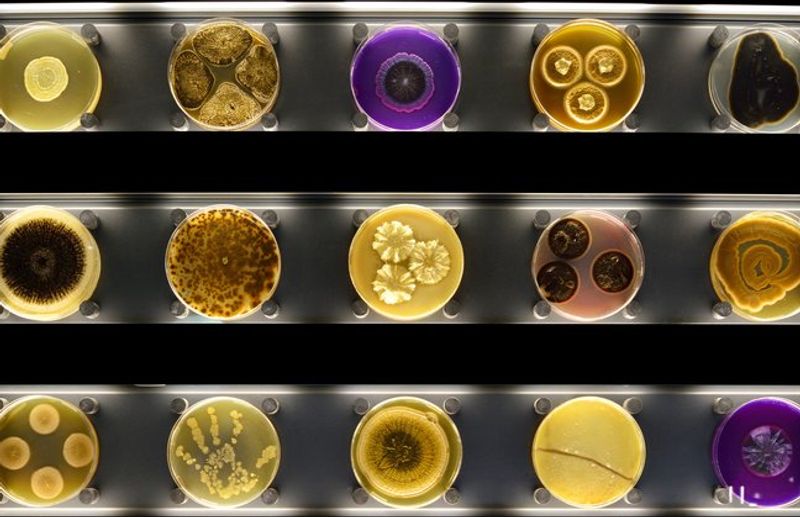
ARTIS-Micropia - Amsterdam, Netherlands

Europe is full of world-class art galleries and history museums, but tucked between the famous ones are some truly bizarre gems that most travelers never find. From a museum built around broken hearts to one dedicated entirely to manure, these places prove that weird and wonderful often go hand in hand.
I visited a few of these myself and walked away with stories I still tell at dinner parties. If you are ready to swap the predictable for the unforgettable, this list is your starting point.
Museum of Broken Relationships – Zagreb, Croatia
Nobody expects to get emotional in a museum full of random household objects, and yet here we are. Zagreb’s Museum of Broken Relationships is exactly what it sounds like: a collection of items donated by people after their relationships ended, each one paired with a short, often gut-punching story.
A pair of garden gnomes. A wedding dress.
An axe. Each piece carries real weight.
Founded in 2006 by two Croatian artists who were, fittingly, an ex-couple, the museum has since traveled the world before finding its permanent home in Zagreb’s Upper Town. The stories range from funny to devastating, sometimes within the same display case.
It is the kind of place that makes you laugh one second and stare at the floor the next.
If you are traveling through Croatia, this is a must-stop. Budget at least an hour, because you will slow down at almost every exhibit without even realizing it.
The Icelandic Phallological Museum – Reykjavík, Iceland
Only Iceland could pull this off with a straight face. The Icelandic Phallological Museum in Reykjavik is entirely dedicated to collecting and displaying phallological specimens from mammals found in Iceland, and it does so with remarkable scientific seriousness.
The collection includes over 280 specimens from more than 90 species.
There is also a growing human section, which is exactly as eyebrow-raising as it sounds. The museum leans into its own absurdity just enough to stay fun without losing its educational credibility.
First-time visitors often walk in smirking and walk out genuinely impressed by how thorough the whole operation is.
It is one of those travel stops that guarantees a great story. Located right in central Reykjavik, it is easy to add to any Iceland itinerary.
Fair warning: the gift shop is memorable. You will either buy something immediately or pretend you did not look.
ARTIS-Micropia – Amsterdam, Netherlands
Most museums ask you to look at big things. Micropia in Amsterdam flips that completely by making the invisible world the entire show.
Opened in 2014 as part of the ARTIS Royal Zoo complex, it is the world’s first museum dedicated entirely to microbes, and it is far more visually stunning than that description suggests.
The exhibits use microscopes, interactive screens, and live cultures to show visitors bacteria, fungi, and other microorganisms up close. There is even a Kiss-O-Meter that calculates how many microbes two people exchange during a kiss.
Romantic? Slightly horrifying?
Both, honestly.
I was skeptical going in, expecting something dry and textbook-ish. Instead, the whole place has this eerie, glowing quality that makes it feel more like an art installation than a science class.
It works brilliantly for curious adults and kids alike. Amsterdam already has great museums, but Micropia earns a special spot on the weird-and-worth-it list.
KattenKabinet – Amsterdam, Netherlands
A Dutch banker named Bob Meijer founded this museum in 1990 as a tribute to his late ginger cat, Tom Meijer. That origin story alone tells you everything you need to know about the level of dedication on display here.
KattenKabinet, or the Cat Cabinet, is a genuine art museum housed in a gorgeous 17th-century Amsterdam canal house, focused entirely on cat-themed works.
The collection spans paintings, drawings, sculptures, and posters from artists including Picasso and Toulouse-Lautrec. It is not kitschy or novelty-driven.
The art is legitimately good, which makes the whole experience feel elevated rather than silly. Real cats also live in the house, wandering between rooms like furry little curators.
Cat lover or not, the setting alone is worth the visit. The canal house is beautiful, the art is interesting, and the vibe is wonderfully eccentric.
It is the kind of place that surprises you by being far more charming than expected.
Disgusting Food Museum – Malmö, Sweden
Sweden’s Disgusting Food Museum opened in Malmö in 2018, and the concept is deceptively smart. It collects foods from around the world that are considered disgusting by at least some cultures, then uses them to explore the science and psychology of disgust.
Fermented shark, maggot cheese, and various animal parts all make the cut.
The point is not just shock value. The museum actively challenges visitors to question why certain foods repel them while others do not, and how culture shapes those reactions entirely.
It is one of the most thought-provoking food experiences you can have without actually eating anything questionable. Though tasting options are available if you are brave enough.
I respect any museum that can make a group of strangers simultaneously gag and reconsider their worldview. The Disgusting Food Museum does exactly that.
It has since traveled to other cities, but Malmö remains its spiritual home. Check the schedule before you visit.
Museo della Merda – Gragnano Trebbiese, Italy
Yes, the name means what you think it means. The Museo della Merda, located on a working farm in the Piacenza province of northern Italy, is a museum built around manure.
Before you close the tab, hear this out: it is actually a genuinely interesting place about ecology, design, and the transformation of waste into something useful.
The museum explores how cow dung from the farm’s dairy herd is converted into biogas, fertilizer, and even building materials. Art installations throughout the space connect waste to history, culture, and sustainability in ways that feel surprisingly sophisticated.
The whole setup challenges the idea that something dismissed as worthless cannot also be inventive and beautiful.
It sounds like a punchline, but visitors consistently leave impressed rather than grossed out. The farm setting adds to the authenticity.
Getting there requires a car, but for anyone interested in sustainable design and genuinely unusual museums, it is absolutely worth the detour.
The Paris Museum of Sewers – Paris, France
Most people come to Paris for the Louvre and the Eiffel Tower. Fewer people know that you can walk through the city’s actual working sewer system as a museum experience, which is a sentence that genuinely improves Paris as a destination.
The Musée des Égouts de Paris has been welcoming curious visitors since 1867.
The tunnels run beneath the streets of the 7th arrondissement and give a surprisingly detailed look at how Paris has managed its underground infrastructure for centuries. Exhibits cover the history of sanitation, the engineering behind the network, and the workers who maintain it.
The smell is present but manageable. You get used to it quickly.
Victor Hugo fans will appreciate that the sewers famously appear in Les Misérables, which adds a literary layer to the whole visit. It is not glamorous, but it is undeniably fascinating.
For travelers who want to see a side of Paris nobody photographs for Instagram, this is the one.
The Paris Catacombs – Paris, France
The Catacombs are not trying to be quirky. They are something else entirely.
Beneath the streets of Paris lies an ossuary containing the remains of approximately six million people, transferred there from overflowing cemeteries beginning in the late 18th century. The bones are arranged deliberately, some in decorative patterns, which makes the whole experience deeply strange and oddly respectful at once.
The official entrance is in the 14th arrondissement, and the visit takes you through about two kilometers of tunnels. The atmosphere is unlike anything above ground.
It is cool, quiet, and genuinely eerie in a way that sticks with you long after you leave.
Tickets sell out fast, so booking in advance is not optional. Skip-the-line options are worth every euro.
I went on a warm summer afternoon and the temperature drop underground was immediate and welcome. The Catacombs are one of those experiences that feels almost unreal while you are in them and absolutely real once you surface.
Museum of Witchcraft and Magic – Boscastle, England
Boscastle is a tiny harbor village in Cornwall, and it holds one of the most serious collections of witchcraft and magical artifacts in the world. The Museum of Witchcraft and Magic opened in 1960 and has been quietly building its reputation ever since.
It is not a Halloween attraction. The exhibits cover folk magic, ritual practice, and occult history with genuine scholarly depth.
The collection includes charms, ritual tools, spell bottles, and objects connected to real historical cases of witchcraft persecution. Some items are genuinely unsettling not because they are theatrical but because of the very real human stories behind them.
The museum treats its subject with respect rather than sensationalism, which makes it far more compelling.
Boscastle itself is worth visiting for the scenery alone, so combining both makes for a brilliant day trip from anywhere in Cornwall. The museum is small but dense.
Give yourself at least ninety minutes and read the labels carefully.
Sex Machines Museum – Prague, Czech Republic
Prague has no shortage of unusual attractions, but this one occupies a category entirely its own. The Sex Machines Museum sits in the heart of the Old Town and spreads across three floors of erotic devices, historical objects, and artifacts spanning several centuries.
It is unapologetically niche and fully committed to that identity.
The collection covers everything from antique curiosities to more modern mechanical inventions, presented with historical context that keeps things more educational than purely provocative. There is also a small cinema on site.
The museum does not pretend to be something it is not, and that honesty is part of what makes it work as a visitor experience.
It is not for everyone, obviously. But for travelers who enjoy the genuinely unusual, it delivers exactly what it promises.
Located just steps from major Old Town landmarks, it is easy to slot into a Prague day without going out of your way. Admission is reasonable.
The Viktor Wynd Museum of Curiosities – London, England
Walking into the Viktor Wynd Museum of Curiosities in East London feels like stepping into the personal collection of someone with extremely specific and wonderfully unhinged taste. That is essentially what it is.
Viktor Wynd has described it as the country’s only curiosity museum, and the collection reflects a worldview that finds equal value in the sacred, the grotesque, and the absurd.
Displays include dodo bones, celebrity hair, taxidermy, occult objects, drug paraphernalia, and works by artists like Damien Hirst. Nothing is organized in a way that would satisfy a conventional curator, and that is entirely the point.
The chaos is deliberate and oddly satisfying once you stop expecting logic.
There is also a cocktail bar downstairs, which is perhaps the most civilized thing about the whole operation. It is a small space, but every square inch rewards attention.
For anyone who loves cabinets of curiosities, this is one of the best modern examples in Europe.
Museum of Romanian Records – Bucharest, Romania
Some museums are built around art. Others are built around obsession.
Bucharest’s Museum of Romanian Records leans hard into the second category, showcasing collections of everyday objects on a scale that crosses from impressive into genuinely mind-bending. Corkscrews, flat irons, trivets, and other seemingly ordinary items appear in quantities that make you question everything you thought you knew about collecting.
The museum celebrates Romanian record-holders and the collectors behind them, turning mundane objects into monuments through sheer volume and dedication. It is the kind of place where you walk past a display of five hundred identical items and feel a weird combination of respect and bewilderment.
Bucharest is still off the radar for many Western tourists, which makes finds like this even more satisfying. The museum has a playful, slightly chaotic energy that suits the subject perfectly.
If you enjoy the wonderfully over-the-top, this one belongs on your Eastern Europe itinerary without question.
The Dog Collar Museum – Kent, England
Leeds Castle in Kent is already one of England’s most beautiful historic sites, which makes it even more delightful that it is also home to the world’s most specific museum. The Dog Collar Museum houses over 130 collars spanning five centuries, from medieval spiked iron examples to elaborately decorated Victorian pieces.
It is oddly specific and unexpectedly elegant.
The collection was donated by a couple named John and Gertrude Hunt in 1979, and it has been charming visitors ever since. Some of the older collars are genuine works of craftsmanship, with engraved metalwork and padlocks that reflect the importance of dogs to their owners across different eras.
The history of pet ownership is surprisingly rich when you look at it through this lens.
It is the kind of exhibit you walk into skeptically and leave genuinely fascinated by. Pair it with a full day at Leeds Castle and the surrounding grounds.
The combination makes for one of Kent’s most memorable days out.
Funeral Carriage Collection – Barcelona, Spain
Barcelona hides this one well. Tucked beneath the city’s main municipal cemetery complex, the Funeral Carriage Collection is exactly the kind of attraction that never makes it onto standard tourist itineraries, which is a genuine shame.
The carriages on display are extraordinary objects, black and gold and impossibly ornate, built for a time when the journey to the grave was treated as a grand ceremonial occasion.
The collection covers funeral rites, symbolism, and the craftsmanship behind the vehicles themselves, giving historical and cultural context that lifts it well above a simple vehicle display. The oldest pieces date back to the 18th century.
Standing next to one of these massive horse-drawn hearses in a dimly lit hall is one of those experiences that is hard to shake.
Entry is affordable and crowds are minimal, which is rare for Barcelona. It pairs well with a visit to the Poblenou neighborhood nearby.
For travelers drawn to the darker, more unusual side of history, this collection is a genuine find.